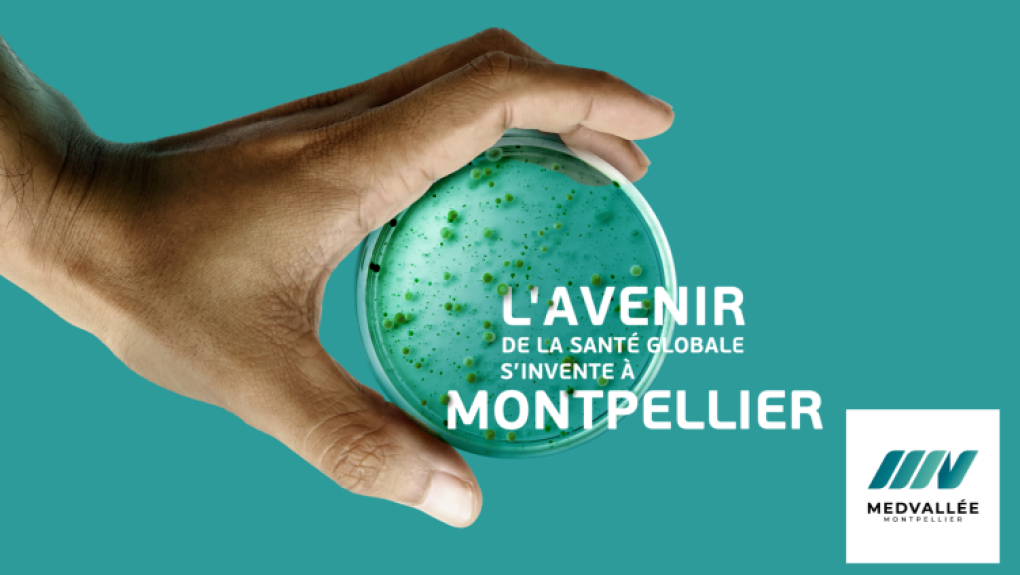
Cap sur MedVallée

Vous êtes un entrepreneur dans le secteur de l'animation, du jeu vidéo, du son/audio, du cinéma, de l'audiovisuel, des effets spéciaux… ? Découvrez sur cette page toutes les actualités, événements, appels à projets à ne pas manquer !
Retrouvez ici toute l’actualité économique du territoire métropolitain.
Vous avez une actualité, un événement, un appel à projets à partager ? Contribuez sur notre site en quelques clics.

Vous travaillez dans le secteur de la programmation informatique, du conseil en systèmes et logic

Vieillissement de la population, handicap, accidents de la vie : l’évolution des besoins en santé

Créée en 2021 et implantée au Crès, Lazar Soft accompagne les directions informatiques, PME, coll
Vous êtes une startup, TPE/PME/grand groupe, chercheur, entrepreneur, partenaire, institutionnel…

Chaque mois, retrouvez ici les actualités du portail et des associations engagées sur le territoi

Au cœur de la Cité Créative à Montpellier, plusieurs espaces se libèrent aux Ateliers Tropisme.

Dirigeants, chefs d'entreprise…, mettre à disposition ses bureaux, le soir et le week-end, p

L'innovation technologique franchit une nouvelle étape au sein du CHU d’Angers avec l'i

La Luciole d'Or brille pour la 6ᵉ édition du World Film Festival in Cannes.